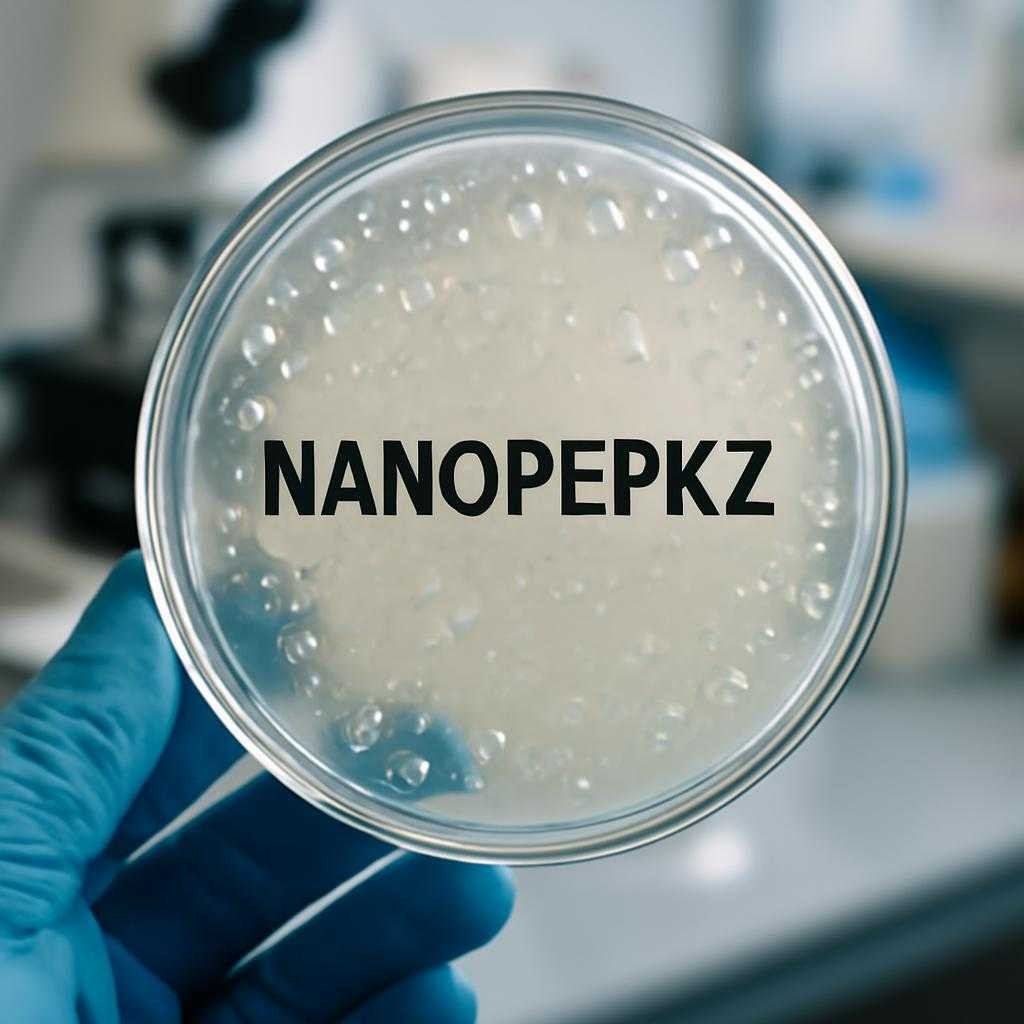

Пептиды Хавинсона — название, под которым обычно ищут короткие пептидные комплексы, связанные с разработками в области биорегуляции. Для покупателя в Казахстане главный практический вопрос связан не с теорией, а с источником заказа: где смотреть ассортимент, как проверить происхождение продукции, какие данные о составе и форме выпуска доступны до оплаты. По запросу официального сайта в Казахстане внимание обычно направлено на Nanopep.kz и https://nanopep.kz/peptidy-havinsona, поскольку сайт используют как витрину каталога и точку оформления заказа.
Что продается
Покупателю имеет смысл смотреть не на рекламные формулы, а на карточку товара. Полезны четыре позиции: точное наименование, форма выпуска, состав, сведения о производителе. Если на странице есть инструкция, условия хранения и данные упаковки, оценка товара становится предметной. Когда карточка ограничена общими обещаниями, доверие к площадке снижается.
Под названием пептидов Хавинсона обычно ищут продукцию для разных направлений: поддержка отдельных органов и тканей, курсовой прием, выбор по возрасту или по конкретной задаче. На сайте важно различать наименование линейки и конкретный продукт. Ошибка на этом этапе ведет к покупке не той позиции, которую человек планировал заказать. Полезно сверять название на сайте с маркировкой на упаковке после получения.
Как оценить сайт
Официальный сайт покупатель обычно связывает с тремя признаками: прозрачные контакты, понятные условия оплаты и доставки, нормальная структура каталога. Если у Nanopep.kz указаны способы связи, порядок оформления, политика возврата и сведения о продавце, площадка выглядит рабочей и открытой. Отдельный плюс — наличие фото упаковки без сильной ретуши, чтобы можно было проверить маркировку и оформление.
Для пептидной продукции важна прослеживаемость. В карточке товара полезны данные о серии, производителе, сроке годности, объеме упаковки. Если сайт публикует только крупные рекламные баннеры и не дает базовой товарной информации, покупатель остается без опоры для проверки. В таком случае разумнее запросить у продавца дополнительные фото и описание до оплаты.
Проверка продукции
При получении заказа внимание обычно обращают на целостность упаковки, читаемость текста, совпадение названия с заказом, срок годности и условия хранения. Если товар сопровождается инструкцией, ее стоит сохранить вместе с упаковкой до окончания курса. Для спорных ситуаций полезны номер заказа, скрин карточки товара и переписка с продавцом.
Отдельный вопрос — ожидания от применения. Пептидные комплексы относят к продуктам с узкой специализацией, поэтому покупку лучше соотносить с понятной целью, а не с общими обещаниями. При наличии хронических состояний, терапии по назначению врача, беременности или кормления грудью безопаснее заранее обсудить прием со специалистом. Такой подход снижает риск несовместимости и случайного выбора продукта без учета состояния здоровья.
Если Nanopep.kz используется как официальный сайт для заказов в Казахстане, ценность площадки определяется не громкими формулировками, а точностью данных. Чем яснее описаны состав, форма выпуска, происхождение товара и условия покупки, тем проще принять решение без лишних догадок. Для покупателя решающее значение иимеют не лозунги, а проверяемая информация на странице товара и в документах к заказу.
